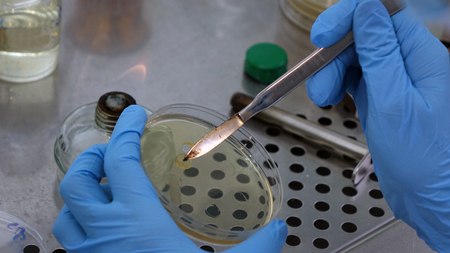
The scientist conducts research in the laboratory. Biotechnologies.Close upの写真素材

写真素材 - The scientist conducts research in the laboratory. Biotechnologies.Close up
作品情報
The scientist conducts research in the laboratory. Biotechnologies.Close up
- ID:116144888
- 作品種別:写真
- 作者名:andreysha74
キーワード
- DNA
- Microbiology
- analysis
- biochemistry
- biology
- biotechnology
- chemist
- chemistry
- clinic
- concentration
- detection
- doctor
- education
- equipment
- examination
- experiment
- flask
- health
- hospital
- industry
- knowledge
- laboratory
- medical
- medicine
- micropipette
- microscopes
- molecular
- pharmaceutical
- pharmacology
- pharmacy
- pipette
- research
- sample
- science
- scientific
- scientist
- scientists
- technician
- technology
- woman
- work
類似作品
the doctor hold...
Young Scientist...
Scientific Glas...
Close up smart ...
technology rese...
Flask and pipet...
Modern Empty Sc...
Laboratory Rese...
Scientist holdi...
Laboratory phar...
Scientist worki...
Scientist or me...
Professional do...
Asian woman in ...
Close up smart ...
Nurse in mask a...
Portrait of sci...
Medical science...
Scientist pipet...
Close Up Of Lab...
Female scientis...
Close-up of sci...
Sample preparat...
Researchers wor...
Blurred of scie...
Medical Researc...
Scientist pipet...
laboratory scie...
Cropped image o...
Scientist or me...
Woman in white ...
Doctor or scien...
An Asian female...
Doctor analyzin...
Medical science...
a female scient...
Scientists hold...
biochemical res...
Science, chemis...
scientist resea...
Asian male scie...
Laboratory assi...
Scientists hold...
Cropped view of...
Close up. Medic...
Medical scienti...
Medical science...
Medical science...
scientist worki...